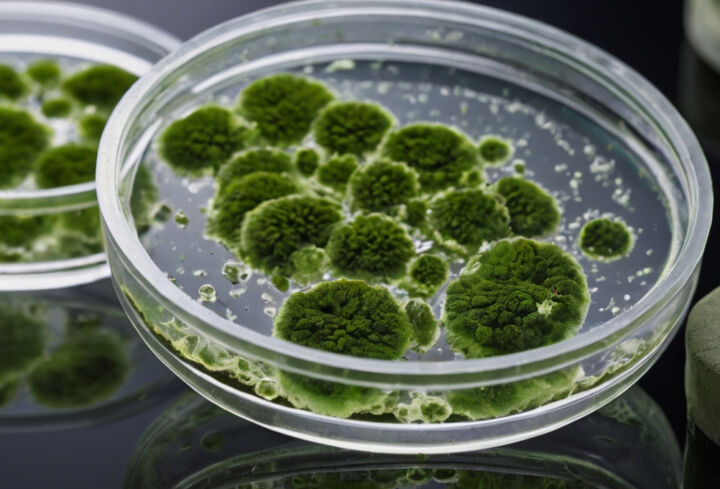

おしゃれな外壁塗装に人気のグレーカラー|おすすめの色と施工例

グレーカラーの外壁は、スタイリッシュで洗練された印象を与え、多くの方に選ばれる人気のデザインです。シンプルでありながら上品さを持ち、さまざまな建築様式にマッチするのが特徴です。
この記事では、グレーカラー外壁を検討中の方へ向けて、色選びのコツや具体的な施工事例を詳しく解説します。
グレーカラーが人気の理由
グレーカラーが人気の理由
グレーが持つ印象や心理的効果

グレーカラーの外壁は、現代の住宅建築において非常に幅広く採用されている人気の色です。
その魅力は、シンプルでありながら洗練された印象を与えるだけでなく、心理的・感覚的な効果にもあります。
1. クールで落ち着いた印象
グレーは「クールで落ち着いた印象」を持つため、住宅の外観に取り入れることでモダンで洗練された雰囲気を演出できます。無彩色であるグレーは視覚的に主張が少なく、周囲の環境と調和しやすい点も魅力です。
また、グレーの濃淡によってシャープさや柔らかさを表現でき、シンプルながらも奥深いデザインが可能です。住宅にグレーを採用することで、上品で落ち着いた印象を与える外観が実現します。
2. リラックス効果
グレーは心理学的に視覚的なリラックス効果をもたらす色とされています。
明るい色や鮮やかな色は目を引く一方、長時間見続けると視覚的な疲労を感じやすくなる場合がありますが、グレーはその点で優れたバランスを持ち、落ち着きを感じさせます。視覚的な刺激が少ないため、長く見続けても不快感が少なく、穏やかな雰囲気を保ちやすいのが特徴です。
他の色との調和が取りやすい
グレーは、インテリアや建築で「中性色」として知られ、その特性が他の色と組み合わせる際に特に活かされます。
穏やかで控えめなグレーは、派手な色や濃い色と合わせると落ち着いた雰囲気を作り出し、逆に明るい色や淡い色と組み合わせると、洗練された上品な印象を引き立てることができます。視覚的にも柔軟性が高く、どんなカラーにもなじみやすいため、個性を活かしつつも全体に統一感を与えられるのが魅力です。
そのため、グレーの外壁は他の素材や色調との調和が取りやすく、周囲の環境や建物全体の雰囲気に合わせた様々な表情を楽しめます。
1.ホワイトとの組み合わせ
グレーカラーとホワイトの組み合わせは、外観全体がシンプルで明るく見え、清潔感やモダンな雰囲気が強調されるため、幅広い層から人気があります。

特にファミリー層の住宅で好まれ、家族が集まる家としての温かみや落ち着きを感じさせます。ホワイトが持つ明るさや純粋なイメージと、グレーの洗練された落ち着きが組み合わさることで、住宅全体にバランスの取れた上品な印象を与えます。
また、ホワイトの面積を増やせば明るさが強調され、グレーの面積を増やせばスタイリッシュでモダンな雰囲気が強まるなど、配分によってさまざまなテイストが楽しめるのも魅力です。
この組み合わせは、周囲の景観とも調和しやすく、住宅街や都市部の住宅でも馴染みやすいデザインとして多く採用されています。
2.木目調カラーとの組み合わせ
グレー外壁と木目調カラー外壁の組み合わせは、ナチュラルで温かみのある雰囲気を作り出し、住宅に居心地の良さと自然な風合いをもたらします。

この組み合わせは、グレーの洗練された印象と木目調の柔らかさが絶妙に調和し、スタイリッシュでありながらも親しみやすい外観を演出します。また、自然の景観とも馴染みやすく、森や山、海などのアウトドア環境に溶け込むデザインとなり、特に自然が多い地域の住宅に最適です。
木目調が持つ暖かみと、グレーの落ち着いた印象が相まって、家族や来客をリラックスさせる穏やかな空間を演出します。さらに、季節や天候によっても異なる表情を見せ、時間と共に経年美を楽しめるのも魅力です。
3.ブラックとの組み合わせ
ブラック外壁とグレー外壁の組み合わせは、モノトーンのスタイリッシュで洗練された雰囲気を生み出し、現代的で都会的な印象を強調します。

ブラックを少量使用することで空間に引き締まったアクセントが加わり、全体にメリハリが生まれます。これにより、無機質で冷たい印象になりがちなモノトーンにも奥行きや立体感が加わり、重厚感と洗練さが引き立ちます。
このため、住宅はもちろん、カフェやレストラン、オフィスビルなどの商業施設にも適しています。ブラックとグレーのバランスを工夫することで、クールでプロフェッショナルな印象を持たせたり、シンプルで落ち着いた雰囲気を演出したりと、さまざまなスタイルが楽しめるのも魅力です。
さらに、モノトーンは時間が経っても古びにくく、時代を問わず人気があり、長期的にスタイリッシュな外観を保つことができます。
おしゃれなグレー外壁の種類
おしゃれなグレー外壁の種類
ライトグレー、ダークグレー、グレージュなどの色味の違い
1. ライトグレー

ライトグレーは、外観に明るさを与えながらも落ち着きのある印象を保つことができます。ライトグレーの特徴は、日の光を反射しやすく、外壁に使用すると建物全体が明るく見えることです。
住宅に与える雰囲気
ライトグレーは特にシンプルな住宅デザインや、明るさを強調したい外観に適しています。
印象
清潔感、開放感
2. ダークグレー

ダークグレーは重厚感や高級感をもたらす色です。高層マンションやモダン住宅など、外観全体をシャープで都会的な印象にしたい際に多く採用されています。
住宅に与える雰囲気
ダークグレーは視覚的に建物が締まった印象を持たせ、特に外壁と窓枠を同じ色調で揃えることで、一体感が生まれます。
印象
重厚感、高級感
3. グレージュ

グレージュは、柔らかさと温かみを兼ね備えた色です。戸建て住宅やナチュラルモダンなデザインの建物に適しており、周囲の景観と調和しやすく、やさしく落ち着いた印象を与えます。
住宅に与える雰囲気
グレージュは建物全体をやわらかく包み込むような印象を持たせ、居心地の良さを引き出します。特に外壁と木目調のドアや窓枠を組み合わせることで、ナチュラルな一体感が生まれ、温かみのある空間を演出します。
印象
温かみ、柔らかい印象
おすすめのグレーカラーと組み合わせ
おすすめのグレーカラーと組み合わせ
屋根、窓枠、ドアなどとの組み合わせ例
1. 屋根との組み合わせ

◆グレーの外壁×グレーの屋根
グレーの外壁に同系色のグレーの屋根を組み合わせると、全体に統一感が生まれ、シンプルでありながらも落ち着きと調和のある印象を与えます。
この組み合わせは、シックでモダンな雰囲気を醸し出し、住宅全体が洗練されたスタイルでまとまります。
特に淡いグレーと濃いグレーを組み合わせることで、さりげないコントラストが生まれ、視覚的に奥行きのあるデザインに仕上がるのが特徴です。この微妙な色の差が、建物に立体感と深みを与え、上品な印象を強調します。
また、グレーは曇りや雨の日でもその美しさが際立ち、天候に左右されにくいため、どんな季節や天候でも落ち着いた外観を保つことができます。さらに、汚れが目立ちにくいというメリットもあり、メンテナンスの面でも優れているため、長期的な使用に適しています。

◆グレーの外壁×ブラックの屋根
グレーの外壁にブラックの屋根を合わせると、全体に引き締まった印象が生まれ、シックで高級感のあるモダンな外観を演出します。
ブラックの屋根がもたらす深みが、外壁との対比で強調され、洗練された都会的な雰囲気を作り出します。この組み合わせは、シンプルながらも存在感があり、特にスタイリッシュで個性的な仕上がりを求める方におすすめです。ブラックの屋根は太陽光を吸収し、昼間は外観がクールに見える一方で、夜間には落ち着いた佇まいが際立ちます。
また、グレーとブラックの色調が相互に引き立て合うことで、住宅全体が品格とモダンさを兼ね備えたバランスの良いデザインに仕上がります。さらに、ブラックの屋根は汚れが目立ちにくく、耐久性にも優れているため、メンテナンス面でも安心です。
この組み合わせは、時代を問わずに人気があり、どのような環境にも馴染む普遍的な魅力を持っています。
2. 窓枠との組み合わせ

◆グレーの外壁×ホワイトの窓枠
グレーの外壁にホワイトの窓枠を組み合わせると、清潔感が漂い、明るく爽やかな印象を与える外観が実現します。
この組み合わせは、シンプルながらもエレガントで、どんなスタイルの住宅にも取り入れやすいデザインです。
特にライトグレーとホワイトの組み合わせは、柔らかく落ち着いた雰囲気を作り出しながらも、さりげない個性が光り、訪れる人に上品で洗練された印象を与えます。
ホワイトの窓枠が光を反射することで、建物全体が明るく見え、外観に軽やかなアクセントを加えるのも大きな魅力です。さらに、ホワイトが持つ清潔感とグレーの落ち着きが相まって、バランスの取れた印象を生み出します。
この配色は、季節や天候に左右されにくく、どのような環境でも美しく映えるため、多くの住宅で採用されています。また、ホワイトの窓枠が光を取り込みやすく、室内にも明るさを感じさせる効果がある点も見逃せません。

◆グレーの外壁×ブラックの窓枠
ブラックの窓枠を組み合わせると、グレーの外壁に引き締まったスタイリッシュなアクセントが加わり、全体に洗練された都会的な印象を与えます。
この配色は、シンプルでありながらも大胆なコントラストが特徴で、建物にモダンな雰囲気をプラスします。特に濃いグレーとブラックの組み合わせは、力強くシャープな印象を生み出し、個性的で現代的なデザインを好む方に最適です。窓枠のブラックが建物のラインを際立たせることで、外観に立体感と奥行きが加わり、視覚的な魅力が高まります。また、ブラックは汚れが目立ちにくく、メンテナンスの面でも実用的です。
この組み合わせは、都市部の住宅や商業施設など、モダンで洗練されたデザインを求める場面で特に映えるでしょう。さらに、夜間の照明や植栽との相性も良く、昼夜を問わず上品でクールな外観を保つことができます。
3. ドアとの組み合わせ

◆グレーの外壁×木目調ドア
木目調のドアは、グレーの外壁に温かみを加える効果があり、冷たくなりがちなグレーの印象を柔らかくし、バランスの取れた外観を作り出します。木目の自然な風合いが、無機質なグレーにぬくもりを加え、親しみやすい印象を与えるのが魅力です。
また、木製のドアや手すりなどの要素を取り入れることで、外観全体が落ち着いた雰囲気に仕上がり、自然との調和が感じられるデザインが完成します。この組み合わせは、ナチュラルな雰囲気を好む方に特におすすめで、温かさと洗練さを兼ね備えたスタイルが実現します。
さらに、木目調のドアは周囲の緑や植栽とも相性が良く、建物が風景に自然に溶け込む効果もあります。アクセントとして木目調を選ぶことで、個性的でありながらもどこか懐かしい安心感のあるデザインを作り上げることができ、訪れる人々にも好印象を与えるでしょう。

◆グレーの外壁×ブラックドア
ブラックのドアを選ぶと、グレーの外壁が持つ洗練された雰囲気がさらに際立ち、外観全体にモダンで引き締まった印象を与えます。
ブラックはシンプルながらも力強さを持つ色で、住宅をよりシャープでスタイリッシュに見せる効果があります。特にダークグレーの外壁やブラックの窓枠と組み合わせると、色調の統一感が生まれ、都会的で高級感のあるデザインに仕上がります。
この配色は、現代的な住宅に特に適しており、洗練された佇まいが建物全体の存在感を高めます。また、ブラックのドアは外壁とのコントラストを活かしつつ、アクセントとしての役割も果たし、建物のデザインにメリハリを加えます。
さらに、夜間の照明や植栽のライトアップとも相性が良く、昼夜を問わずエレガントな雰囲気を保つことができます。ブラックのドアを採用することで、時代を超えて愛されるスタイリッシュで上質な外観が完成します。
グレーカラー外壁の注意点とメンテナンス
グレーの外壁は、シックで落ち着いた印象を与え、どんな建物にも調和しやすい上、汚れが比較的目立ちにくいという実用的なメリットもあります。
しかし、その美しさを長く保つためには、定期的なメンテナンスが欠かせません。特に、カビや苔の発生を防ぐための適切な洗浄や、経年劣化による色褪せを抑える塗装のメンテナンスが重要です。
この記事では、グレー外壁を維持するために知っておきたいポイントを2つに分けて詳しく解説します。
1.色褪せと汚れへの対策

グレーの外壁は、日光や風雨に晒され続けると、時間と共に色が薄れ、特に明るいライトグレーは色褪せが目立ちやすくなります。これを防ぐには、高対候性の塗料を選ぶことが効果的です。
また、定期的な清掃も大切ですが、高圧洗浄機を頻繁に使用するのは避けたほうがよいでしょう。強い水圧によって塗膜が削れてしまうと、汚れがつきやすくなり、外壁自体が傷つくリスクもあります。
外壁に劣化のサインが見え始めた場合には、早めに再塗装を検討するのが長持ちさせる秘訣です。塗装会社では、劣化具合を診断し、最適なメンテナンス時期を提案してくれるため、定期的な点検も推奨されます。
2.カビ・苔の予防と管理方法
グレーは控えめな色のため、湿気の多い地域や影ができやすい場所では、カビや苔が生えた際に目立ちやすくなります。特に日当たりの悪い面には、湿気が溜まりやすく、苔やカビの発生リスクが高まります。
対策としては、防カビ・防藻機能を持つ塗料を使用するほか、塗装の際に防カビ剤を塗料に添加することで、カビや苔の発生を予防できます。
また、適度な頻度でのスポンジを使っての洗浄は有効ですが、やりすぎると外壁に負担がかかります。
適切なタイミングでの清掃と、劣化の兆候が見られた場合の塗装が、外壁の美しさと耐久性を維持するポイントです。
グレーカラーの選び方のポイント
グレーの外壁を選ぶ際には、カラーシミュレーションや色見本を活用すると、仕上がりのイメージを具体的に確認できるため安心です。
特にグレーカラーは、明るさや周囲の環境によって印象が変わりやすいため、事前に確認することが大切です。
1.カラーシミュレーションで確認

カラーシミュレーションを使うと、住宅の写真に好みのグレーをシミュレーションし、全体のバランスを確認できます。
例えば、ライトグレーを選ぶと、住宅全体が明るく爽やかに見え、濃いめのダークグレーなら引き締まったモダンな印象になります。シミュレーションでは、窓枠や屋根との色合わせもできるため、理想の組み合わせを事前に検討できます。
自分でもできるカラーシミュレーション
webサイト上で利用できるカラーシミュレーションサイトもあります。
自分の家と似た家を探して試してみましょう。
2.色見本で細部のチェック

グレーは光の当たり方で微妙に異なる表情を見せるため、自然光の下で色見本をチェックするとよりリアルな印象がつかめます。
また、周囲の環境や近隣との調和も考慮しつつ、気に入ったグレーを選ぶことで、満足度の高い外観が完成します。
まとめ
グレーカラーの外壁塗装は、落ち着きと高級感を持ちながら、他の色との組み合わせで多彩な印象を演出できる魅力的な選択肢です。
ライトグレーで明るく爽やかに、ダークグレーでモダンで引き締まった雰囲気に仕上がります。また、ホワイトや木目、ブラックなどの窓枠やドアと組み合わせることで、より個性的で洗練された外観が実現します。
カビや色褪せへの対策を取りながら、カラーシミュレーションや色見本を活用して理想のグレーを選びましょう。





